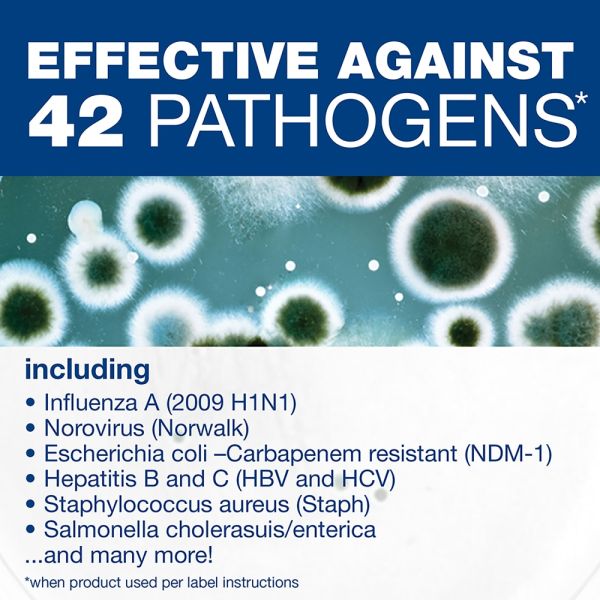
Image 7

Top Seller
Comet Professional Disinfecting-Sanitizing Bathroom Cleaner, 128 Oz Bottle, Case Of 3
Product #:
ODFN9491738





 +4
+4View All
Product Description
Comet Professional Disinfecting-Sanitizing Bathroom Cleaner, 128 Oz Bottle, Case Of 3
Efficiently clean and deodorize frequently-used restrooms with Comet Professional Disinfecting-Sanitizing Bathroom Cleaner. The tough formula cuts right through soap scum and other bathroom soils on virtually any surface to leave them sparkling.
- Non-abrasive multi-surface cleaner is efficient on porcelain, fiberglass, ceramic, Formica, enamel, stainless steel, tile, synthetic marble and chrome.
- Disinfecting cleaner cuts through tough soap scum and penetrates tough soils.
- Deodorizing design leaves restrooms smelling clean.
- No rinsing or scrubbing required — simply spray on and wipe off.
- Intended for industrial and hospital use.
Loading...
Product Specifications
-
Brand NameComet
-
Container TypePour Bottle
-
Country of OriginUS
-
FeaturesPhenol Free
-
FragranceClean
-
ManufacturerTHE PROCTER & GAMBLE COMPANY
-
Manufacturer Part Number22570CT
-
Product FormLiquid
-
Product LineProfessional Disinfecting-Sanitizing Bathroom Cleaner
-
Product TypeRestroom Surface Cleaner
-
RefurbishedN
-
TypeBathroom Cleaner